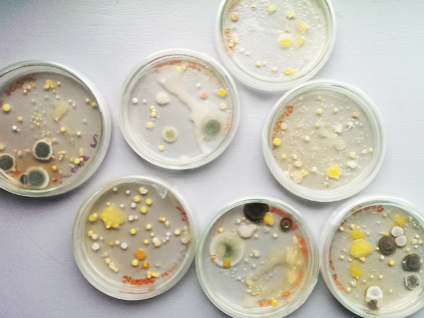
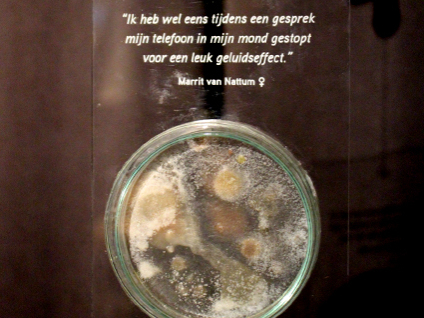

Pattern carrier
biodesign
Onze telefoons zijn persoonlijk en kostbaar. We praten met ze. We tikken op ze. We houden ze dichtbij ter bescherming en ze bevatten inhoud die van diepe betekenis is. Maar als we beter kijken, zouden we iets nogal eigenaardigs zien. Door het opkomende gebied van 'Biodesign' te combineren samen met grafische vormgeving, heb ik ontdekt dat onze kostbare smartphones broeinesten zijn voor bacteriën die per persoon verschillende en fascinerende patronen onthullen.